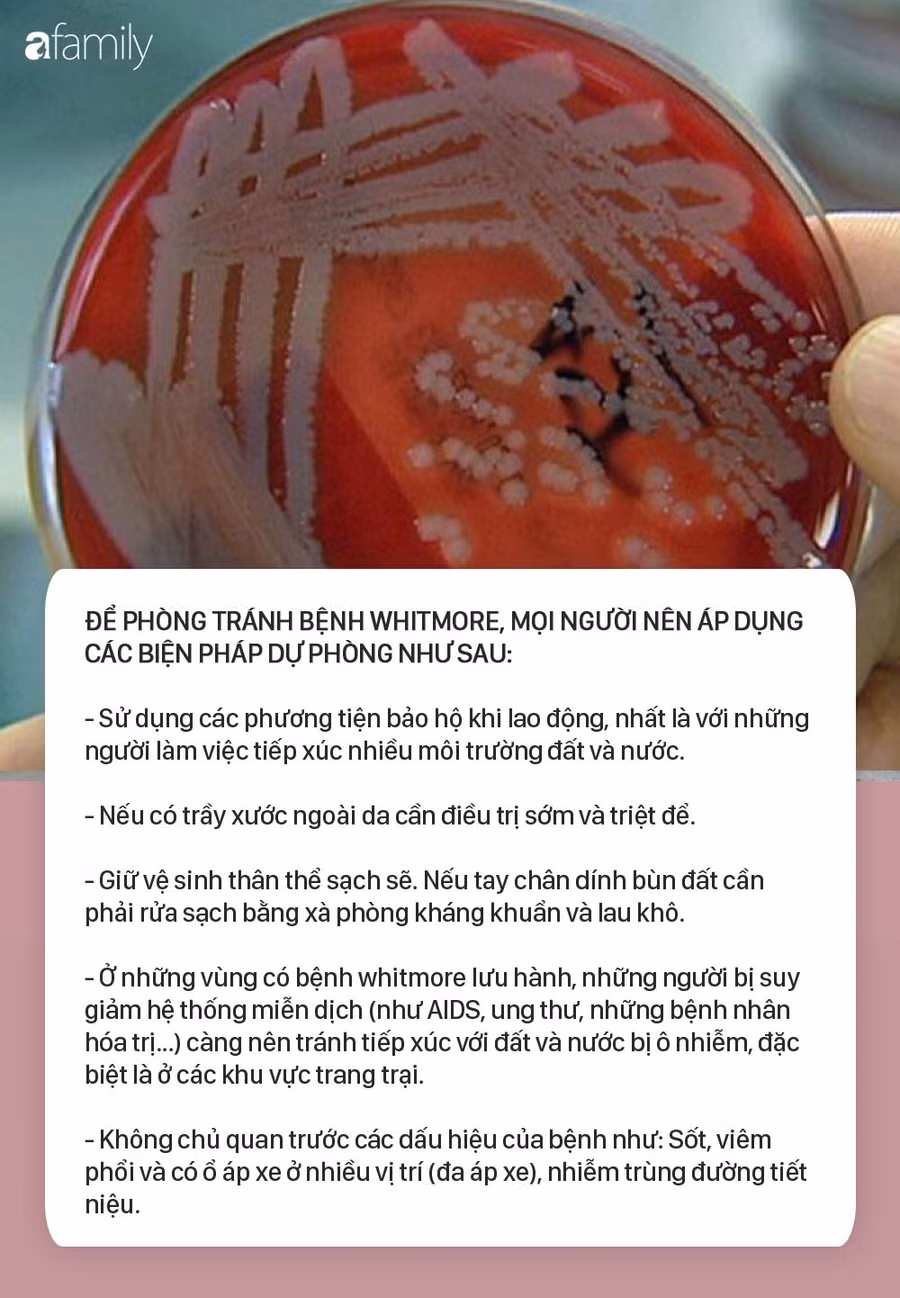
whitmore-6

Mới đây, thông tin từ Trung tâm Bệnh Nhiệt đới, Bệnh viện Bạch Mai cho biết riêng trong tháng 8/2019, Trung tâm đã tiếp nhận 12 ca mắc whitmore - căn bệnh được ví là do vi khuẩn "ăn thịt người" gây ra, trong đó có 4 ca đã tử vong.
Trong khi người dân còn vô cùng bàng hoàng với thông tin này thì ngay sau thời điểm đó, bệnh viện Đa khoa tỉnh Hà Tĩnh cũng thông báo phát hiện 1 bệnh nhân mắc vi khuẩn này.
Người bệnh là người đàn ông 61 tuổi, có tiền sử bị bệnh đái tháo đường type II. Mặc dù được điều trị tích cực bằng kháng sinh phối hợp nhưng bệnh nhân đáp ứng chậm với quá trình điều trị, do đó bệnh viện đã tiến hành làm thủ tục chuyển bệnh nhân lên tuyến trên để tiếp tục điều trị.

Mới đây nhất là công bố của bệnh viện Sản Nhi Nghệ An về trường hợp 3 trẻ nhiễm bệnh Whitmore "ăn thịt người". Theo báo cáo của bệnh viện thì 3 bệnh nhân (14 tuổi, 11 tuổi và 10 tuổi) đều có bệnh cảnh áp xe viêm tuyến nước bọt mang tai.
Kết quả cấy mủ, xét nghiệm máu của 3 bệnh nhi dương tính với bệnh Whitmore.


Bác sĩ Nguyễn Thị Huyền Ngân, khoa Tai Mũi họng Bệnh viện Sản Nhi Nghệ An cho biết, bệnh Whitmore (hay Melioidosis) là một bệnh lây nhiễm gây ra bởi vi khuẩn Gram âm Burkholderia pseudomallei gây bệnh cảnh nhiễm trùng máu.

Hiện nay whitmore là căn bệnh chưa có vắc-xin tiêm phòng, cũng chưa có bất kỳ khuyến cáo nào về sử dụng kháng sinh dự phòng. Do đó những biện pháp phòng tránh sau đây mặc dù rất căn bản nhưng chúng ta không được chủ quan.
Để phòng tránh bệnh Whitmore, mọi người nên áp dụng các biện pháp dự phòng như sau:
- Đối với những người làm việc tiếp xúc nhiều môi trường đất và nước phải có phương tiện bảo hộ lao động, nếu có trầy xước ngoài da cần điều trị sớm và triệt để.
- Đảm bảo vệ sinh thân thể sạch sẽ, đặc biệt là bàn tay bàn chân luôn phải sạch. Nếu tay chân dính bùn đất cần phải rửa sạch bằng xà phòng kháng khuẩn và lau khô trước khi muốn làm việc gì tiếp theo.
- Người bệnh tiểu đường, bệnh phổi và bệnh thận mạn tính có nguy cơ dễ mắc bệnh này với các biểu hiện lâm sàng đa dạng: sốt cao, đau cơ, có các ổ nhiễm khuẩn trên da, áp xe cơ, áp xe gan lách, viêm phổi... Bệnh có thể gây tử vong nhanh nếu không được chẩn đoán đúng và điều trị kịp thời.
- Đối với người bình thường, hạn chế tiếp xúc với bùn đất sẽ tránh nguy cơ bị vi khuẩn tấn công. Vi khuẩn này có trong đất, bùn và đường lây nhiễm chủ yếu do vùng da tổn thương tiếp xúc trực tiếp với vi khuẩn hoặc hít phải các hạt bụi đất chứa vi khuẩn này.
- Đặc biệt, ở những vùng có bệnh whitmore lưu hành, những người bị suy giảm hệ thống miễn dịch (như AIDS, ung thư, những bệnh nhân hóa trị...) càng nên tránh tiếp xúc với đất và nước bị ô nhiễm, đặc biệt là ở các khu vực trang trại.
- Không chủ quan trước các dấu hiệu của bệnh như: Sốt, viêm phổi và có ổ áp xe ở nhiều vị trí (đa áp xe), nhiễm trùng đường tiết niệu.
- Tránh tiếp xúc với máu và chất dịch cơ thể của người bị nhiễm bệnh.
Đặc biệt, cao điểm của các ca bệnh thường xảy ra vào mùa mưa, tập trung từ tháng 7 đến tháng 11. Do đó, những người làm việc tiếp xúc nhiều môi trường đất và nước nhất định phải sử dụng các phương tiện bảo hộ lao động, nếu có trầy xước ngoài da cần điều trị sớm và triệt để.
Đây được coi là bệnh nguy hiểm bởi các triệu chứng lâm sàng của bệnh rất mơ hồ, chẩn đoán khó, dễ nhầm lẫn với nhiều bệnh khác nhưng lại có thể gây tử vong nhanh chóng.
Tỷ lệ tử vong của bệnh Whitmore có thể lên đến 50-60%. Đối với những trường hợp nhiễm khuẩn cấp có thể tử vong trong vòng 1 tuần kể từ khi phát bệnh. Bệnh whitmore còn có nhiều biến chứng nguy hiểm.





































